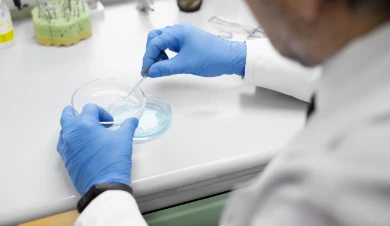

Our Mechanism of Action
Telomerase Activation


Neurodegenerative
Science
The neuroprotective effects of telomerase reverse transcriptase (TERT) in the brain and spinal cord were previously demonstrated by us and by others.
Our compounds demonstrated remarkable therapeutic results in various murine models of neurodegenerative diseases, in a dose- and time-dependent manner.
Our findings support the role of TERT activation in preserving neuronal integrity, reducing inflammation, and improving motor and cognitive function in efficacy models of ALS and Alzheimer’s disease.
In the hSOD1 Tg
murine models of ALS, treatment with AGS-499 delayed the onset and progression of the disease, increased the survival of motor neurons in the mice spinal cord, and increased survival of the mice.
When tested on primary murine hippocampal neurons which were subjected to amyloid beta toxicity, treatment with AGS resulted in increased neuronal survival.
In-vitro testing of AGS
effects on human mesenchymal stem cells derived from ALS and MS patients demonstrated increased survival and ameliorated oxidative stress.
In the 5XFAD murine
model of Alzheimer Disease, AGS treatment reduced amyloid beta plaque burden and improved cognitive behavior.
In human microvessels from coronary artery disease patients, treatment with AGS-499 restored normal vasodilation and demonstrated ability to reverse vascular aging and oxidative damage, re-establishing healthy endothelial function.
AGS treatment in diabetic mice protected pancreatic β-cells, significantly lowered fasting glucose, and improved glucose tolerance. It also preserved kidney structure and normalized creatinine clearance.
AGS compounds stimulated hair regeneration in both newborn and adult mice, increasing the number and activation of hair follicles. Immunofluorescence analyses showed elevated telomerase expression and stem-cell activation within follicles, demonstrating clear rejuvenation of skin and hair tissues.
AGS compounds rejuvenated reproductive function in both sexes with powerful anti-aging effects. In females, they increased ovulation, hormone levels, and embryo count; in males, they boosted sperm production, motility, and restored fertility after damage.
Anti Aging
Science
Our compounds demonstrate strong rejuvenation and anti-aging effects.
By activating telomerase, AGS compounds promote mitochondrial protection, reduce oxidative stress, and preserve cellular vitality.
Our findings support their potential to reverse age-related cellular decline and extend tissue healthspan, as shown across multiple models of cardiovascular, metabolic, reproductive, and hair regrowth.
Pipeline
Team

Prof. Esther Priel, DSc
Founder, CEO & CSO

Daniella Dayan, B.Sc., MBA
Chief Operating Officer

Dr. Helena Grinberg-Rashi,
Ph.D., MBA
Senior Clinical and Regulatory Advisor

Dr. Elad Bar Gil, MD
Chief Medical Officer

Dr. Hananel Elul, Ph.D
Researcher

Dr. Tatyana Glukovsky, Ph.D
Researcher
Scientific Advisory Board

Prof. Gal Ifergane, MD
Head of the Brain Medicine Division,
Soroka Medical Center

Prof. David Stepensky, Ph.D
Prof. of Pharmacology,
Ben-Gurion University

Mr. Iftach Seri, M.Sc. MBA
CEO, CTS Ltd. - pharmaceutical company, Israel
Selected
Scientific
Publications
Eitan E, Tichon A, Gazit A, Gitler D, Slavin S, Priel E.
Novel telomerase-increasing compound in mouse brain delays the onset of amyotrophic lateral sclerosis
EMBO Mol Med. 2012 Apr;4(4):313-29. doi: 10.1002/emmm.201200212. Epub 2012 Feb 20.
Tichon A, Eitan E, Kurkalli BG, Braiman A, Gazit A, Slavin S, Beith-Yannai E, Priel E.
Oxidative Stress Protection by Novel Telomerase Activators in Mesenchymal Stem Cells Derived from Healthy and Diseased Individuals
Curr Mol Med. 2013 Jul;13(6):1010-22. doi: 10.2174/1566524011313060013.
Baruch-Eliyahu N, Rud V, Braiman A, Priel E.
Telomerase increasing compound protects hippocampal neurons from amyloid beta toxicity by enhancing the expression of neurotrophins and plasticity related genes
Sci Rep. 2019 Dec 2;9(1):18118. doi: 10.1038/s41598-019-54741-7.
Events & Media

30/04/2026
Excellence Week Webinar

07/04/2026
Female Fertility Article has been Published

01/07/2025
About Neuromagen with Founder Esther Priel – KAN 11 Feature

10/05/2025
Selected for the Israeli Delegation to the SelectUSA Investment Summit, Washington, D.C., for two consecutive years (2024–2025).

19/04/2024
Breaking Ground in ALS Research – featured by Ynet

27/09/2023
Neuromagen’s Rise in Israel’s Biotech Scene - Featured by TheMarker
19/11/2024
Neuromagen Pharma's team were invited to participate in the round table held by the US Office of Economic Development.

09/07/2025
In Conversation with Prof. Esther Priel: The Vision Behind Neuromagen - featured by Pnima Magazine.

Prof. David Stepensky and Mr. Iftach Seri have joined the scientific advisory board.
Strong Intellectual Property Position
Over 30 patents
All 8 major markets
New IP.
Once granted,
protects
AGP-499
through 2045
Cover for composition & use
Indications:
Neurodegenerative, Fertility, Diabetes,
Cardiovascular diseases, Hair & skin,
AMD
Contact Us
Address
Beer Sheva High Tech Park, 77 HaEnergya St.
P. O. Box 5316, Beer Sheva, Israel
Website
Privacy Policy | Accessibility Statement
© 2026 Neuromagen Pharma
Design & Development imarkimage
HaEnergia 77, Beer Sheva